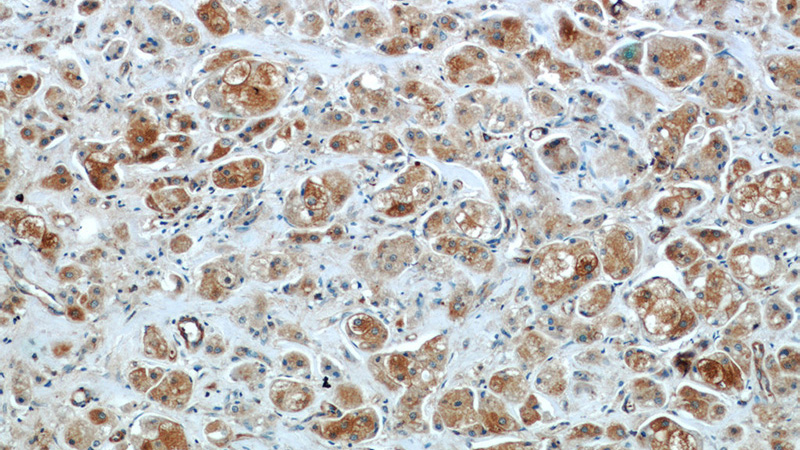

-
Product Name
BRCA1 antibody
- Documents
-
Description
BRCA1 Rabbit Polyclonal antibody. Positive IHC detected in human breast cancer tissue, human lung cancer tissue. Positive WB detected in HeLa cells, A431 cells, HEK-293 cells, MCF-7 cells. Observed molecular weight by Western-blot: 100 kDa
-
Tested applications
ELISA, IHC, WB
-
Species reactivity
Human; other species not tested.
-
Alternative names
BRCA1 antibody; BRCAI antibody; BRCC1 antibody; breast cancer 1 antibody; early onset antibody; BROVCA1 antibody; IRIS antibody; PSCP antibody; RING finger protein 53 antibody; RNF53 antibody
- Immunogen
-
Isotype
Rabbit IgG
-
Preparation
This antibody was obtained by immunization of BRCA1 recombinant protein (Accession Number: BC115037). Purification method: Antigen Affinity purified.
-
Clonality
Polyclonal
-
Formulation
PBS with 0.02% sodium azide and 50% glycerol pH 7.3.
-
Storage instructions
Store at -20℃. DO NOT ALIQUOT
-
Applications
Recommended Dilution:
WB: 1:500-1:5000
IHC: 1:20-1:200
-
Validations

HeLa cells were subjected to SDS PAGE followed by western blot with Catalog No:117223(BRCA1 Antibody) at dilution of 1:1000
Immunohistochemistry of paraffin-embedded human breast cancer slide using Catalog No:117223(BRCA1 Antibody) at dilution of 1:50
-
Background
BRCA1, also named as RNF53, plays a central role in DNA repair by facilitating cellular response to DNA repair. It is required for appropriate cell cycle arrests after ionizing irradiation in both the S-phase and the G2 phase of the cell cycle. The BRCA1-BARD1 heterodimer coordinates a diverse range of cellular pathways such as DNA damage repair, ubiquitination and transcriptional regulation to maintain genomic stability. BRCA1 acts by mediating ubiquitin E3 ligase activity that is required for its tumor suppressor function. It is involved in transcriptional regulation of P21 in response to DNA damage. BRCA1 is required for FANCD2 targeting to sites of DNA damage. It may function as a transcriptional regulator. BRCA1 inhibits lipid synthesis by binding to inactive phosphorylated ACACA and preventing its dephosphorylation. The antibody is specific to BRCA1.
Related Products / Services
Please note: All products are "FOR RESEARCH USE ONLY AND ARE NOT INTENDED FOR DIAGNOSTIC OR THERAPEUTIC USE"
